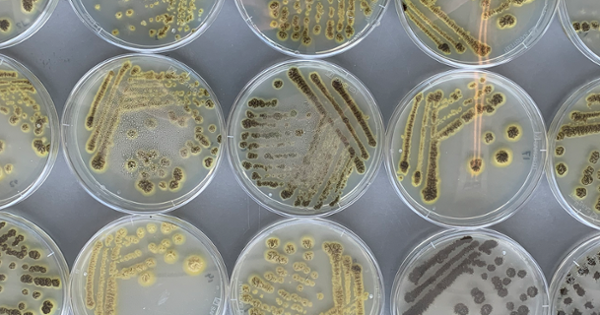
Grant for research into fungus that could make vegan cheese cheaper and more sustainable

‘s Lands grootste kruidenier geeft om jongeren geen zier’, schreeuwt een spandoek tijdens een kantoorbezetting bij Ahold in 1981. ‘Werkende jongeren werden lang niet serieus genomen. Toch hebben ze zichzelf op de kaart gezet’, weet historicus Rosa Kösters.
Universiteit Leiden
Officieel Mastodon-account van de Universiteit Leiden. Over wetenschap, opleidingen, evenementen en studentenleven. http://universiteitleiden.nl
Posts
Officieel Mastodon-account van de Universiteit Leiden. Over wetenschap, opleidingen, evenementen en studentenleven. http:// universiteitleiden.nl
Officieel Mastodon-account van de Universiteit Leiden. Over wetenschap, opleidingen, evenementen en studentenleven. http:// universiteitleiden.nl
Officieel Mastodon-account van de Universiteit Leiden. Over wetenschap, opleidingen, evenementen en studentenleven. http:// universiteitleiden.nl
Officieel Mastodon-account van de Universiteit Leiden. Over wetenschap, opleidingen, evenementen en studentenleven. http:// universiteitleiden.nl
Wie is de baas in de Straat van Hormuz? Zeerechtspecialist Hilde Woker duidt de complexe situtie ➡️ https://www.universiteitleiden.nl/nieuws/2026/04/geen-gewoon-stuk-zee-wie-is-de-baas-in-de-straat-van-hormuz
Officieel Mastodon-account van de Universiteit Leiden. Over wetenschap, opleidingen, evenementen en studentenleven. http:// universiteitleiden.nl
Officieel Mastodon-account van de Universiteit Leiden. Over wetenschap, opleidingen, evenementen en studentenleven. http:// universiteitleiden.nl
Leidse onderzoekers en partners krijgen een subsidie van 1,3 miljoen euro om met behulp van schimmels dierlijke melkeiwitten voor vegan kaas te maken.
Leiden researchers and partners have been awarded a 1.3-million-euro grant to produce milk protein for vegan cheese using fungi. While this process is not new, the use of another fungus could make the protein cheaper and more sustainable.
Officieel Mastodon-account van de Universiteit Leiden. Over wetenschap, opleidingen, evenementen en studentenleven. http:// universiteitleiden.nl
Officieel Mastodon-account van de Universiteit Leiden. Over wetenschap, opleidingen, evenementen en studentenleven. http:// universiteitleiden.nl
Onze nieuwsbrief staat weer online. Met deze week:
🗽 Amerikaanse censuur raakt academici in Nederland
🥦 Groenten uit Amsterdam: dak met moestuin kan voedselketen versterken
🧑💻Jongeren over polarisatie: ‘Politici moeten het goede voorbeeld geven’
Officieel Mastodon-account van de Universiteit Leiden. Over wetenschap, opleidingen, evenementen en studentenleven. http:// universiteitleiden.nl
Officieel Mastodon-account van de Universiteit Leiden. Over wetenschap, opleidingen, evenementen en studentenleven. http:// universiteitleiden.nl
Wat vind jij van onze nieuwsberichten over wetenschap? Vul de enquête in en draag bij aan goede wetenschapscommunicatie. + Maak kans op een universitair cadeau. Iedereen va 18 kan meedoen, muv alumni, studenten en (oud)medewerkers. ➡️https://leidenuniv.eu.qualtrics.com/jfe/form/SV_9v1eoW7nC7UnyBM
Officieel Mastodon-account van de Universiteit Leiden. Over wetenschap, opleidingen, evenementen en studentenleven. http:// universiteitleiden.nl
Officieel Mastodon-account van de Universiteit Leiden. Over wetenschap, opleidingen, evenementen en studentenleven. http:// universiteitleiden.nl
🪱 Levend of niet? Deze 3D-geprinte robotjes zwemmen en navigeren als dieren! Deze microrobots zwemmen, navigeren, nemen hun omgeving waar en passen zich aan op een manier die opvallend ‘levend’ lijkt.
🪱 Alive or not? Tiny 3D printed robots that swim and navigate just like animals! These microscopic robots that can swim, navigate, and adapt — without sensors, software, or external control. edu.nl/fk48a
Officieel Mastodon-account van de Universiteit Leiden. Over wetenschap, opleidingen, evenementen en studentenleven. http:// universiteitleiden.nl
Officieel Mastodon-account van de Universiteit Leiden. Over wetenschap, opleidingen, evenementen en studentenleven. http:// universiteitleiden.nl
Zelfs als een grens officieel niet meer bestaat, maken mensen in de praktijk uit of er vrije doorgang is of niet. Ook aan de Pools-Duitse grens, waar promovendus Maryla Klajn onderzoek deed.
Even when a border has officially disappeared, it is still people who decide whether others may cross freely. This was also true for the Polish-German border, where PhD candidate Maryla Klajn spent six months conducting fieldwork. ‘They initially saw me as the enemy.’
Officieel Mastodon-account van de Universiteit Leiden. Over wetenschap, opleidingen, evenementen en studentenleven. http:// universiteitleiden.nl
Officieel Mastodon-account van de Universiteit Leiden. Over wetenschap, opleidingen, evenementen en studentenleven. http:// universiteitleiden.nl
Hoe weerbaar is Nederland bij een energiecrisis, zoals die nu dreigt door de oorlog in het Midden-Oosten? En wat kunnen we doen om ons beter voor te bereiden? Twee van onze experts reageren. Zo zegt hoogleraar crisismanagement Arjen Boin: 'Landelijke en lokale overheden zouden contact moeten leggen met lokale verenigingen en hen instrueren wat ze moeten doen in tijden van crises.'
https://www.universiteitleiden.nl/nieuws/2026/03/hoe-kwetsbaar-is-nederland-bij-een-energiecrisis
#crisis #energie #iran
Officieel Mastodon-account van de Universiteit Leiden. Over wetenschap, opleidingen, evenementen en studentenleven. http:// universiteitleiden.nl
Officieel Mastodon-account van de Universiteit Leiden. Over wetenschap, opleidingen, evenementen en studentenleven. http:// universiteitleiden.nl
Onderzoekers van het LUMC en de universiteiten van Granada en Almería ontdekten een darmbacterie die samenhangt met sterkere spieren bij mensen en muizen. Deze ontdekking helpt mogelijk om spierkracht te behouden.
Researchers at LUMC, the Universities of Granada and Almería have found a gut bacterium that is associated with stronger muscles in people and mice. Their findings hint at the potential for new probiotics to support muscle strength and healthy aging.
https://www.universiteitleiden.nl/en/news/2026/03/strong-muscles-start-in-the-gut
Officieel Mastodon-account van de Universiteit Leiden. Over wetenschap, opleidingen, evenementen en studentenleven. http:// universiteitleiden.nl
Officieel Mastodon-account van de Universiteit Leiden. Over wetenschap, opleidingen, evenementen en studentenleven. http:// universiteitleiden.nl
Drie dagen achter elkaar onderzoeksdata verzamelen op een festival met ruim 65.000 potentiële proefpersonen: heb je een origineel onderzoeksidee voor Lowlands Science? Dien dan jouw voorstel in vóór 27 maart 2026!
Fancy spending three days collecting research data at a festival with over 65,000 potential research participants? And do you have an original research idea? Submit your proposal for Lowlands Science by 26 March 2025!
Officieel Mastodon-account van de Universiteit Leiden. Over wetenschap, opleidingen, evenementen en studentenleven. http:// universiteitleiden.nl
Officieel Mastodon-account van de Universiteit Leiden. Over wetenschap, opleidingen, evenementen en studentenleven. http:// universiteitleiden.nl
Met zelfgebouwde boten strijden studenten uit de hele wereld tegen elkaar in de Monaco Energy Boat Challenge. De teams bouwen raceboten die varen op duurzame brandstof. De Leidse bestuurskundestudent Damiaan Bertrams doet mee met een team van de TU Delft. #waterstof https://www.universiteitleiden.nl/nieuws/2026/03/studenten-racen-in-monaco-met-vliegende-boot-op-vloeibare-waterstof
Officieel Mastodon-account van de Universiteit Leiden. Over wetenschap, opleidingen, evenementen en studentenleven. http:// universiteitleiden.nl
Officieel Mastodon-account van de Universiteit Leiden. Over wetenschap, opleidingen, evenementen en studentenleven. http:// universiteitleiden.nl
De aanvallen van de VS en Israël op Iran worden door critici van het regime bejubeld, maar ook uiterst bezorgd gadegeslagen. Ze zorgen voor een gevaarlijk domino-effect in de regio en daarbuiten. Leidse experts geven hun visie op de mogelijke gevolgen.
https://www.universiteitleiden.nl/nieuws/2026/03/oorlog-in-het-midden-oosten-wat-zijn-de-gevolgen
Officieel Mastodon-account van de Universiteit Leiden. Over wetenschap, opleidingen, evenementen en studentenleven. http:// universiteitleiden.nl
Officieel Mastodon-account van de Universiteit Leiden. Over wetenschap, opleidingen, evenementen en studentenleven. http:// universiteitleiden.nl
Vici-beurzen voor onderzoek naar antistoffen, sterrenstelsels en inheemse volkeren https://www.universiteitleiden.nl/nieuws/2026/02/vici-beurzen-voor-onderzoek-naar-antistoffen-sterrenstelsels-en-inheemse-volkeren
Officieel Mastodon-account van de Universiteit Leiden. Over wetenschap, opleidingen, evenementen en studentenleven. http:// universiteitleiden.nl
Officieel Mastodon-account van de Universiteit Leiden. Over wetenschap, opleidingen, evenementen en studentenleven. http:// universiteitleiden.nl
Drones, digitale afweer en geïmproviseerde oplossingen bepalen grotendeels het slagveld. Nederlandse en Oekraïense experts duidden op een symposium de situatie aan het front. Wat zijn volgens hen de lessen? https://www.universiteitleiden.nl/nieuws/2026/02/vier-jaar-oorlog-in-oekraine-dit-kan-europa-leren-van-het-slagveld
Officieel Mastodon-account van de Universiteit Leiden. Over wetenschap, opleidingen, evenementen en studentenleven. http:// universiteitleiden.nl
Officieel Mastodon-account van de Universiteit Leiden. Over wetenschap, opleidingen, evenementen en studentenleven. http:// universiteitleiden.nl
Een geweldpleging zoals een mishandeling zorgt voor ontzetting, pijn en verdriet. Dit geweld wordt vaak gezien als zinloos of beestachtig. Toch heeft geweld betekenis voor de daders, bepleit geweldonderzoeker Don Weenink in zijn oratie op 2 maart.
Violence such as assault causes pain, shock and distress. It is often seen as savage or senseless. But for those who commit it, violence has meaning, argues violence researcher Don Weenink in his inaugural lecture. #geweld
https://www.universiteitleiden.nl/en/news/2026/02/violence-has-meaning-what-drives-people-to-use-it
Officieel Mastodon-account van de Universiteit Leiden. Over wetenschap, opleidingen, evenementen en studentenleven. http:// universiteitleiden.nl
Officieel Mastodon-account van de Universiteit Leiden. Over wetenschap, opleidingen, evenementen en studentenleven. http:// universiteitleiden.nl
Het is misschien wel de mooiste traditie: op het verjaardagsfeest van de universiteit geven Leidse wetenschappers les aan kinderen op basisscholen. Maar liefst 75 hoogleraren stonden op 44 scholen in de regio voor de klas.
It may be the best tradition of them all: on the university’s birthday, its professors go to primary schools to teach a special lesson. This year, 75 professors visited 44 local schools. https://www.universiteitleiden.nl/en/news/2026/02/a-real-professor-in-the-classroom-did-you-sweat-in-the-sweat-room
Officieel Mastodon-account van de Universiteit Leiden. Over wetenschap, opleidingen, evenementen en studentenleven. http:// universiteitleiden.nl
Officieel Mastodon-account van de Universiteit Leiden. Over wetenschap, opleidingen, evenementen en studentenleven. http:// universiteitleiden.nl
Natuurkundigen en technici bouwden een microscoop die in één meting maar liefst vier belangrijke karakteristieken van een materiaal meet. Deze microscoop brengt onderzoek en innovaties op het gebied van quantummaterialen in versnelling.
Physicists have built a microscope that can measure no fewer than four key properties of a material in a single scan. The instrument can accelerate research and innovation in the field of #quantum materials.
https://www.universiteitleiden.nl/en/news/2026/01/a-new-microscope-for-the-quantum-age-finally-seeing-how-quantum-materials-behave #physics
Officieel Mastodon-account van de Universiteit Leiden. Over wetenschap, opleidingen, evenementen en studentenleven. http:// universiteitleiden.nl
Officieel Mastodon-account van de Universiteit Leiden. Over wetenschap, opleidingen, evenementen en studentenleven. http:// universiteitleiden.nl
Een internationaal team publiceerde hun onderzoek in Nature. Terwijl elders in Europa grote migratiestromen en snelle genetische veranderingen plaatsvonden, bleef de prehistorische bevolking in de Lage Landen opmerkelijk stabiel.
An international team published their research in Nature. While large migration flows and rapid genetic changes were taking place elsewhere in Europe, the prehistoric population in the Low Countries remained remarkably stable.
https://www.universiteitleiden.nl/nieuws/2026/02/dna-studie-onthult-opmerkelijke-stabiliteit-prehistorische-bevolking-lage-landen
Officieel Mastodon-account van de Universiteit Leiden. Over wetenschap, opleidingen, evenementen en studentenleven. http:// universiteitleiden.nl
Officieel Mastodon-account van de Universiteit Leiden. Over wetenschap, opleidingen, evenementen en studentenleven. http:// universiteitleiden.nl
Hoera! 🎉 Vandaag vieren we de oprichting van onze universiteit maar liefst 451 jaar geleden. 🎂🎓
De viering vindt plaats in de historische Pieterskerk. De ceremonie is te volgen via onze livestream: https://www.universiteitleiden.nl/agenda/extra/2026/02/dies-natalis-2026
Officieel Mastodon-account van de Universiteit Leiden. Over wetenschap, opleidingen, evenementen en studentenleven. http:// universiteitleiden.nl
Officieel Mastodon-account van de Universiteit Leiden. Over wetenschap, opleidingen, evenementen en studentenleven. http:// universiteitleiden.nl
De Nederlandse universiteiten reageren positief op de nieuwe coalitieplannen. Er wordt flink ingezet op investeren in onderwijs, onderzoek en innovatie, de grote bezuinigingen van het vorige kabinet worden teruggedraaid. Ook in Leiden heerst optimisme, al is er ook reden voor waakzaamheid.
Officieel Mastodon-account van de Universiteit Leiden. Over wetenschap, opleidingen, evenementen en studentenleven. http:// universiteitleiden.nl
Officieel Mastodon-account van de Universiteit Leiden. Over wetenschap, opleidingen, evenementen en studentenleven. http:// universiteitleiden.nl
Onderzoekers begrijpen PALB2‑mutaties, een oorzaak van erfelijke borstkanker, beter. Door te testen welke mutaties de werking van het PALB2-eiwit beïnvloeden, kunnen artsen veel beter inschatten bij welke mutaties er een verhoogd risico op #borstkanker is.
Researchers have made a breakthrough in understanding PALB2 mutations, an important cause of hereditary breast cancer. This helps doctors better identify which mutations increase #breastcancer risk.
Officieel Mastodon-account van de Universiteit Leiden. Over wetenschap, opleidingen, evenementen en studentenleven. http:// universiteitleiden.nl
Officieel Mastodon-account van de Universiteit Leiden. Over wetenschap, opleidingen, evenementen en studentenleven. http:// universiteitleiden.nl
Van wateroverlast en extreme hitte tot verlies van biodiversiteit: steden wereldwijd krijgen te maken met de gevolgen van klimaatverandering. Arnold Tukker en Mingming Hu (CML) zoeken naar oplossingen in het Nederlands-Chinese ReSURE2-project, dat 1,1 miljoen euro ontvangt.